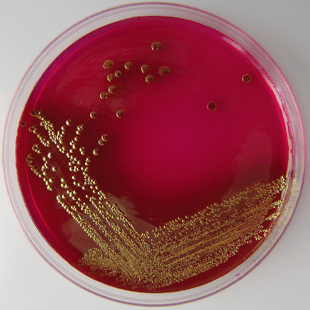
Zelf bacteriën kweken

Wij wonen op de aarde. De aarde is de derde planeet van ons zonnestelsel. In totaal zijn er acht planeten die allemaal om de zon draaien. Eigenlijk staan alle planeten op een rij. Dit zijn: Mercurius, Venus, Aarde, Mars, Jupiter, Saturnus, Uranus en Neptunus. Tussen al die planeten zit de ruimte. Heel veel ruimte. In dit proefje ga je een model maken van het zonnestelsel en zet je de planeten op een rij. Je gaat meten en zien wat de afstand is tussen de verschillende planeten.
Nodig:
- stuk touw van 5 meter lang.
- grote knoop of kraal (voor de zon)
- 8 kleinere kralen (voor de planten)
- meetlint
- potlood
- schaar
- vel papier
- plakband
Stappen:
De ruimte tussen de planten is in het echt heel groot. We gaan een model maken dat een stuk kleiner is. Dat heet een schaalmodel. De afstand tussen de planeten is zo groot dat we voor het schaalmodel gebruik maken van een rekensommetje. Elke centimeter touw is in het echt 10 miljoen kilometer. De planeten kunnen we niet zo klein maken. Als we dat wel doen worden ze zo groot als een korrel zout.
Alle planeten hebben eigen kleur. Voor Mercurius kan je geel gebruiken en voor Venus oranje. De aarde is natuurlijk blauw en de planeet Mars ziet er rood uit. Jupiter en Saturnus zijn wat grotere planeten, dus je mag ook wat grotere kralen gebruiken. Jupiter ziet er oranje en bruin uit en Saturnus is beige. De grootte van Uranus en Neptunus zit tussen Jupiter en de Aarde in. Uranus is licht groen en Neptunus is blauw (of paars). Natuurlijk kan je ook je eigen kleuren gebruiken. Maak het lekker vrolijk.
Als eerste maak je het centrum van het zonnestelsel vast: De zon. Het leukst is het als je een grote gele kraal of knoop kan gebruiken. Zorg dat hij goed vastzit.
Het is belangrijk dat de zon goed vastzit. Als we de planten gaan vastmaken, meten we eerst de afstand. Dat doe je steeds vanaf de zon. Je meet dus (nog) niet de afstand tussen de planeten.
Leg nu je meetlint langs het touw. Op 6 centimeter van de zon kan je de eerste kraal (een kleintje) vastmaken. Dit is Mercurius. In het echt ziet Mercurius er geel uit, dus gebruik een kleine gele kraal als je die hebt.
Met Mercurius op z’n plek kan je oranje kraal gebruiken voor Venus. Je meet nu 11 centimeter vanaf de zon en knoopt de kraal vast. Voor de andere planeten neem je de volgende afstanden:
| Aarde | 15 cm |
| Mars | 28 cm |
| Jupiter | 78 cm |
| Saturnus | 143 cm |
| Uranus | 287 cm |
| Neptunus | 450 cm |
Als je alle planeten op hun plek hebt vastgeknoopt, mag je ze een naam geven. Je schrijft met je potlood de naam van de planeet op je vel papier. Knip hier vervolgens kleine naamkaartjes van. De naamkaartjes kan je vervolgens bij de planeten plakken.
Vragen:
- Als de planten hangen kan je narekenen wat de echte afstanden zijn. Op hoeveel miljoen kilometer staat de Aarde van de zon?
- En Mars en Neptunes?
- Pluto is geen planeet meer, maar een dwergplaneet. Als je Pluto ook op je touw wil knopen, hoeveel meter lang denk je dat je touw dan moet zijn?
Meer weten?
Je kunt heel veel meer leren over ons zonnestelsel door ernaar te kijken. Er zijn zelfs clubs en verenigingen voor kinderen die het leuk vinden om naar sterren en planten te kijken. De Jongerenwerkgroep voor sterrenkunde is zo´n club. Ze organiseren vaak leuke dingen over de ruimte.
Wist je in de stad of een dorp veel minder sterren en planeten ziet dan buiten de stad? Als je op vakantie bent lijkt het soms of er veel meer sterren zijn. Onze vrienden van Het Klokhuis hebben onderzocht waarom dat is. Ze zijn daarvoor speciaal naar een van de grootste telescopen van de wereld gegaan.


Tijdens het Weekend van de Wetenschap kan je op meer dan 200 locaties een kijkje nemen terwijl dat normaal niet kan. Je mag bijvoorbeeld backstage bij het Douane Laboratorium of bij de Rotterdamse haven. Ook kunnen bezoekers bij ESA/ESTEC alleen gedurende dit weekend naar testruimtes die anders gesloten zijn voor publiek. Hier kun je testmodellen bekijken van satellieten die in de ruimte zijn geweest of misschien loop je wel een astronaut tegen het lijf.


Stappen: